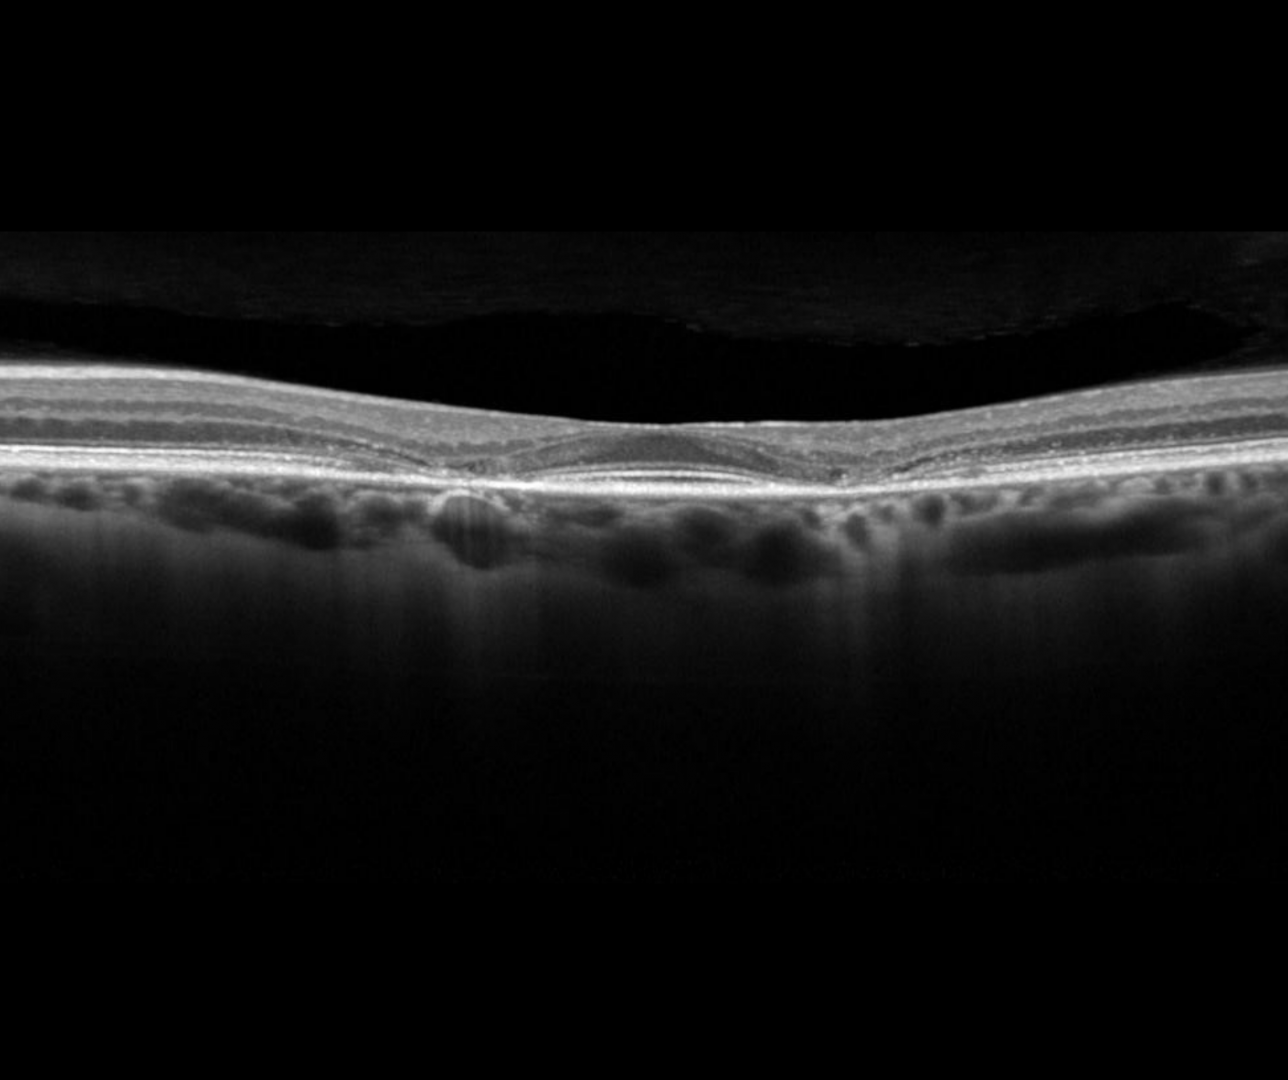

Overview
Plaquenil (hypdroxychloroquine) is commonly used for dermatologic and rheumatologic inflammatory conditions, and more recently sometimes used for diabetes, heart disease and as an adjunct with other cancer therapies. It may, however have toxic retinal effects requiring the prescribing physician to consider cessation of the mediation.
Chloroquine can also induce retinal toxicity and may have similar effects to those described here.
Risks factors for hydroxychloroquine toxicity is a high dosage (>5.0mg/kg real weight), long duration of use (>5 years), renal disease, use of tamoxifen and concomitant renal disease.
Cessation of the medication does not reverse the retinopathy and, in fact, it may continue to worsen even after all medication is stopped.
Hydroxychloroquine retinopathy occurs bilaterally and presents with rings of hypo and hyper pigmentation surrounding the fovea.
Fundus autofluorescence imaging may show increased hyper-autofluorescence that signals early photoreceptor damage and precede thinning on OCT. As the condition progresses, a central bull’s eye pattern of atrophy (hypofluorescence) will be seen.
OCT imaging shows disruption of the parafoveal ellipsoid zone in the early stages. In later stages, the outer retinal layers can be involved. A ‘flying saucer’ sign may be seen on an OCT line scan which describes preservation of the subfoveal layers but perifoveal loss of the ellipsoid zone (EZ) on either side.
A 10-2 threshold visual field may show central depressions, advancing to a ring scotoma over time. In Asian patients, the retinopathy may occur in the extramacular region instead of centrally. In these cases, a wider test pattern (24-2 or 30-2) on visual fields should be used.
Anterior eye changes in the form of corneal verticillata may also occur as a result of hydroxychloroquine toxicity.
Case Example
-
Case 1
A 58 year old Middle Eastern female who was taking plaquenil for 3 years but ceased when damage was found 8 years ago. The patient reports that the vision in the right eye has subjectively worsened over last 12 months. Her best corrected visual acuity is 6/6 (20/20) in each eye.
Fundus photo and red-free image (right eye)
More infoFundus photo and red-free image (left eye)
More infoOptomap and fundus autofluorescence images (right eye - top, left eye - bottom)
More infoSpectralis OCT volume and line scans (right eye)
More infoSpectralis OCT volume and line scans (left eye)
More infoSITA Standard 10-2 visual fields
More info
Differential Diagnosis
References
Yusuf, I. H., Sharma, S., Luqmani, R., & Downes, S. M. (2017). Hydroxychloroquine retinopathy. Eye (London, England), 31(6), 828–845.